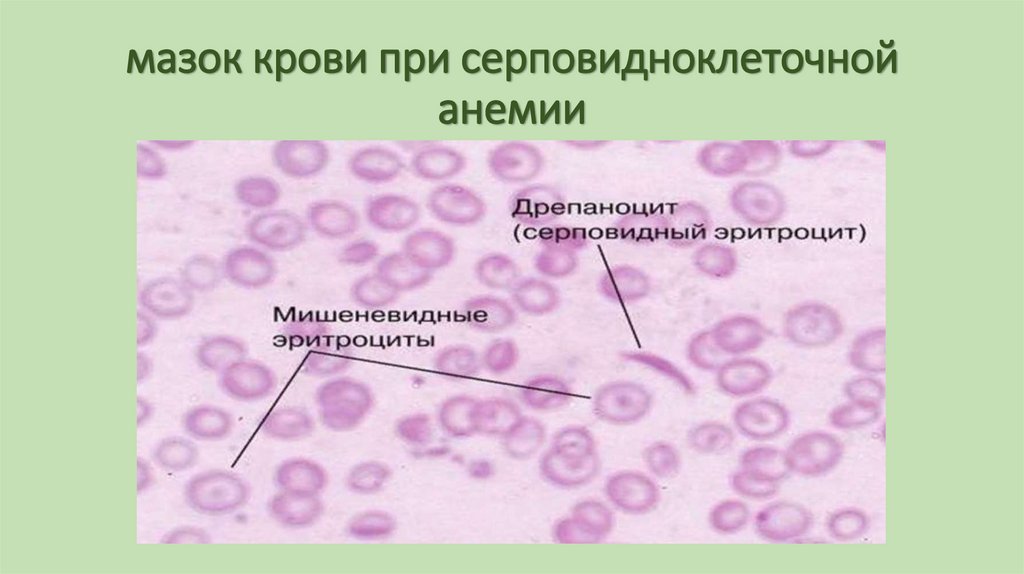
мазок крови при серповидноклеточной анемии
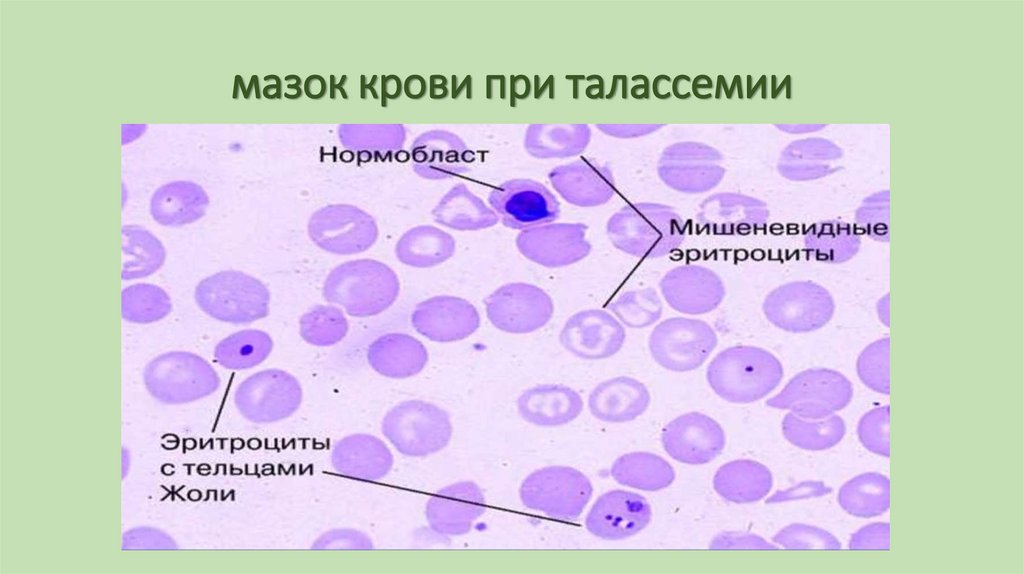
мазок крови при талассемии
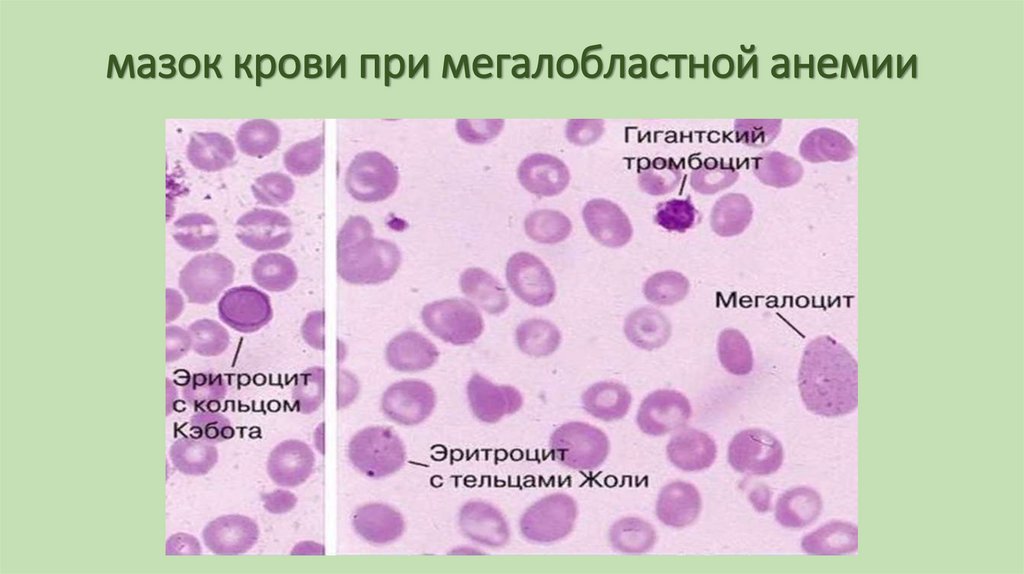
мазок крови при мегалобластной анемии
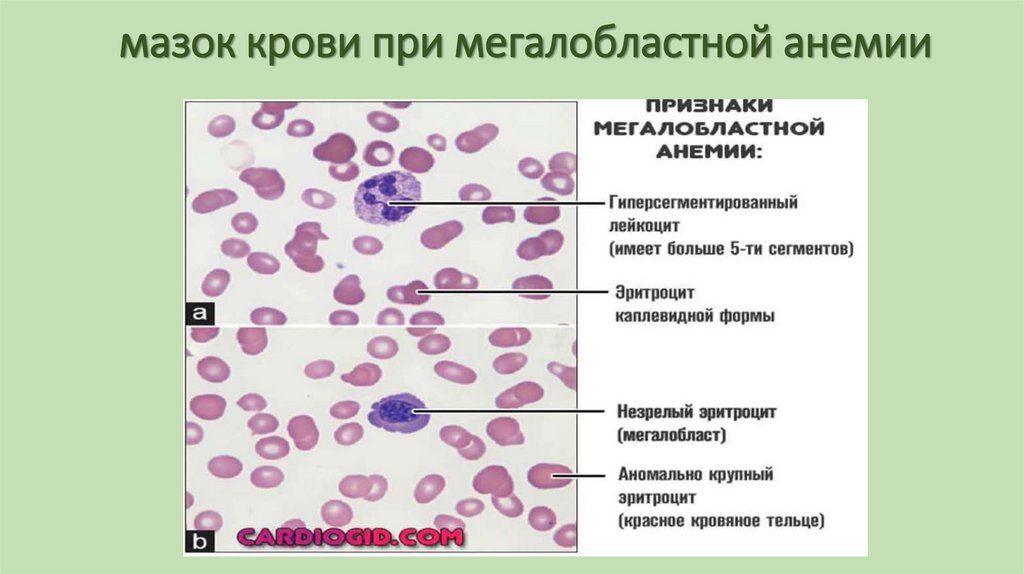
мазок крови при мегалобластной анемии
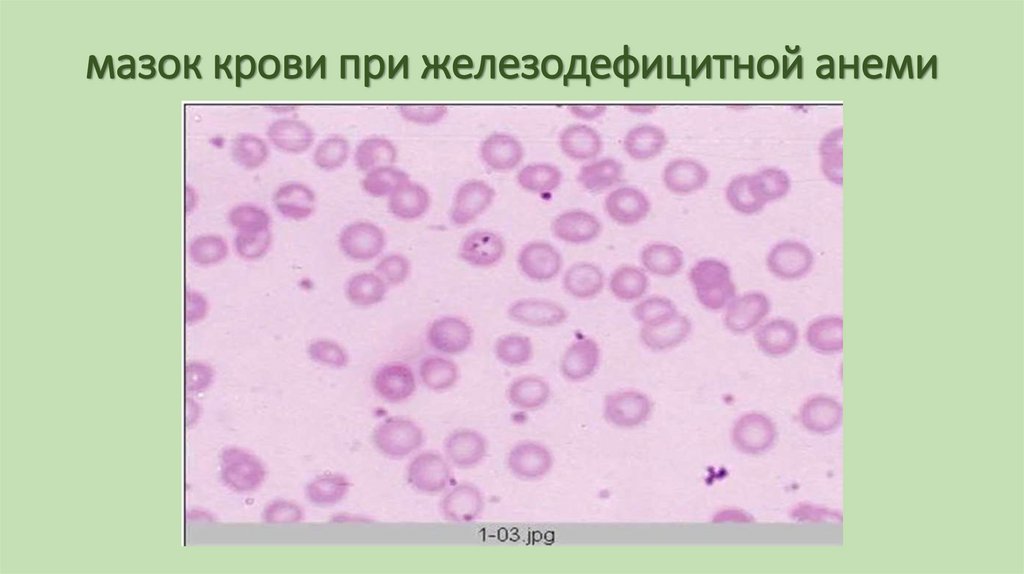
мазок крови при железодефицитной анеми

Similar presentations:
Патология крови 1 Microsoft PowerPoint
1. ПАТОЛОГИЯ СИСТЕМЫ КРОВИ
Функциональные, морфологические ирегуляторные особенности системы крови
влияющие на этиологию и патогенез
патологических процессов в этой системе.
2. ОБЩИЕ ВОПРОСЫ
Кровь –важнейшая составная часть организмаобеспечивающая его гомеостаз.
Основные функции:
1. дыхательная (перенос кислорода и углекислого газа )
2. транспортная (доставляет питательные вещества и
БАВ)
3. дезинтоксикационная (выводит токсические
вещества)
4. регуляторная (регуляция КОС и водного баланса)
3. ОБЩИЕ ВОПРОСЫ
Количество крови составляет 7-8% от массы его тела.(объем крови у человека весом около 70кг составляет
около 5 л). При этом 3,5 -4 литра циркулирует в
сосудистом русле и составляют объем циркулирующей
крови (ОЦК), а 1,5 – 2 литра депонировано в сосудах
брюшной полости, легких, подкожной клетчатки и др.
тканей.
4. ОБЩИЕ ВОПРОСЫ
Отношение объема форменных элементов крови кобъему плазмы называют гематокритом (Ht).
В 1 литре крови доля форменных элементов (в
основном эритроцитов) составляет у мужчин 0,41 – 0,53 л
(Ht 41-53%) у женщин 0,36 – 0,48 л (Ht 36– 48%).
5. ОБЩИЕ ВОПРОСЫ
От количества крови зависит величина АД и работасердца, функция почек и др. органов и систем.
Лейкоциты обеспечивают клеточный и гуморальный
иммунитет.
Тромбоциты вместе с плазменными факторами
свертывания крови останавливают кровотечение.
6. ОСОБЕННОСТИ СИСТЕМЫ КРОВИ
• Генетическая обусловленность размножения,дифференцировки, обмена веществ и структуры всех
кровяных ростков, ведущая к изменениям генетической
регуляции, является причиной заболеваний в системе
крови (лейкозы, гемолитическая анемия и др.)
7. ОСОБЕННОСТИ СИСТЕМЫ КРОВИ
Высокая митотическая активность гемопоэтическойткани, обуславливает ее высокую поражаемость при
действии мутагенных факторов: химические мутагены,
вирусы, ионизирующая радиация, цитостатики, дефицит
пластических материалов (железа, фолиевой кислоты, В12, белков).
Это приводит к развитию дефицитных анемий, лейкозов,
возникновению
мутантных
клонов
лимфоцитов
продуцирующих антитела против собственных клеток
крови (аутоиммунные анемии , тромбоцитопении и др.).
8. ОСОБЕННОСТИ СИСТЕМЫ КРОВИ
Регуляция образования клеток крови с помощьюпоэтинов, при дефиците которых возникает патология.
Патогенные агенты (вирусы, бактерии, эндо- и
экзогенные химические вещества), поступающие в кровь
могут вызвать лизис кровяных клеток и нарушение их
антигенной структуры обуславливающие их вторичный
цитолиз вследствие аутоиммунных реакций.
Повреждение сосудов, вызывающее кровопотерю, при
которой уменьшается общий объем крови и нарушаются
ее функции.
9. ОСОБЕННОСТИ СИСТЕМЫ КРОВИ
О нарушениях в системе крови свидетельствуютизменения:
• 1. общего объема крови
• 2. количества, структуры и функции клеток крови –
вследствие
патологии
кроветворения
или
кроверазрушения.
• 3. гемостаза
• 4. биохимических и физико-химических свойств крови
10. ОСОБЕННОСТИ СИСТЕМЫ КРОВИ
Патологические изменения возникают:1. при действии патогенных факторов непосредственно на
систему крови.
2. в результате нарушений ее нейрогуморальной
регуляции.
3. при поражении других органов и систем, т.е. вторично.
Вторичные изменения обусловлены ее
функциональными особенностями (увеличением числа
эритроцитов при гипоксии, увеличение числа лейкоцитов
при инфекционных болезнях, увеличение числа
тромбоцитов при гемостазе).
11. ОСОБЕННОСТИ СИСТЕМЫ КРОВИ
Патологиясистемы
крови
может
проявляться
самостоятельными заболеваниями – гемофилия, анемия
Аддисона-Бирмера, лейкоз, так и гематологическими
синдромами,
сопровождающими
болезни
других
органов и систем ( эритроцитоз при пороках сердца,
нейтрофильный лейкоцитоз при гнойных процессах).
12. НАРУШЕНИЕ ОБЩЕГО ОБЪЕМА КРОВИ
Эти нарушения проявляются в виде гиповолемии игиперволемии, т.е. уменьшения или увеличения объема
крови по сравнению с нормой (нормоволемией).
Показателем объемного соотношения является
гематокрит.
13. НАРУШЕНИЕ ОБЩЕГО ОБЪЕМА КРОВИ
Гиповолемия нормоцитемическая – уменьшениеобъема крови без изменения гематокрита. Возникает
сразу при острой кровопотери и сохраняется до тех пор,
пока жидкость из тканей не перейдет в кровь (Ht в
норме).
Гиповолемия олигоцитемическая – уменьшение объема
крови с преимущественным уменьшением клеток
(эритроцитов). Наблюдается при острой кровопотере в
тех случаях, когда поступление крови и тканевой
жидкости в кровеносное русло не компенсирует объем и
особенно состав крови (Ht ниже нормы ).
14. НАРУШЕНИЕ ОБЩЕГО ОБЪЕМА КРОВИ
Гиповолемия полицитемическая – уменьшение объемакрови вследствие уменьшения объема плазмы при
относительном увеличении содержания эритроцитов.
Развивается при обезвоживании организма (понос, рвота
и т.д.), шоке (выход жидкости в ткани из-за повышения
проницаемости сосудов), (Ht выше нормы)
15. НАРУШЕНИЕ ОБЩЕГО ОБЪЕМА КРОВИ
Гиперволемия нормоцитемическая – увеличениеобъема крови при сохранении нормального гематокрита.
Возникает сразу после переливания большого количества
крови. Однако, вскоре жидкость покидает кровеносное
русло, а эритроциты остаются, что ведет к сгущению
крови. При усиленной физической работе такая
гиперволемия обусловлена поступлением в общий
кровоток крови из депо.
16. НАРУШЕНИЕ ОБЩЕГО ОБЪЕМА КРОВИ
Гиперволемия олигоцитемическая – увеличение объемакрови за счет плазмы. Развивается при задержке воды в
организме при заболевании почек, при введении
кровезаменителей.(Ht ниже нормы).
Гиперволемия полицитемическая - увеличение объема
крови за счет нарастания количества эритроцитов.
Наблюдается при снижении содержания кислорода,
вследствие опухолевого роста (эритремия) (Ht выше
нормы).
17. НАРУШЕНИЕ ОБЩЕГО ОБЪЕМА КРОВИ
Нормоволемия олигоцитемическая – возникает прианемии, вследствие кровопотери (через 1-2 суток, когда
объем крови нормализовался за счет тканевой жидкости,
а количество эритроцитов еще не восстановилось),
нарушении гемопоэза, гемодилюция. (Ht ниже нормы).
Нормоволемия полицитемическая – при переливании
небольших количеств эритроцитарной массы гемоконцентрация.(Ht выше нормы).
18. ЗНАЧЕНИЕ ГИПОВОЛЕМИИ И ГИПЕРВОЛЕМИИ
Гиповолемия – сопровождается нарушениемдыхательной и транспортной функций эритроцитов,
трофической, экскреторной, защитной, регуляторной
функций крови, что отражается на гомеостазе организма.
Гиперволемия обуславливает увеличение нагрузки на
сердце. В случае одновременного увеличения
гематокрита (полицитемическая гиперволемия)
увеличивается вязкость крови, что может быть причиной
нарушений микроциркуляции и способствовать
образованию тромбов
19. КРОВОПОТЕРЯ – ОПРЕДЕЛЕНИЕ.
Кровопотеря – это патологический процесс,возникающий вследствие кровотечения и
характеризующийся сложным комплексом
патологических нарушений, направленных против
уменьшения ОЦК и гипоксии, обусловленной снижением
дыхательной функции крови.
20. ПРИЧИНЫ КРОВОПОТЕРИ
1. нарушение целостности сосуда при ранении илипоражении патологическим процессом (атеросклероз,
опухоль, туберкулез);
2. повышение проницаемости сосудистой стенки
(лучевая болезнь);
3. понижение свертываемости крови (геморрагический
диатез)
21. ТЕЧЕНИЕ И ИСХОД КРОВОПОТЕРИ
Зависит от:1. от особенностей самого кровотечения (скорости, величины,
вида поврежденного сосуда, механизм повреждения);
2. скорости включения и выраженности компенсаторных реакций
организма;
3. пола и возраста;
4. предшествующих и сопутствующих кровопотере состояний
(охлаждение, травма, заболевания сердца, глубокий наркоз).
Серьезную опасность для жизни человека представляет потеря
50% ОЦК, смертельной является потеря крови свыше 60%.
22. ПАТОГЕНЕЗ ОСТРОЙ КРОВОПОТЕРИ
В патогенезе выделяют :1. начальную стадию, характеризующуюся уменьшением ОЦК,
нормоцитемической гиповолемией, понижением АД, гипоксией
циркуляторного типа.
2. компенсаторную стадию, которая обусловлена включением
комплекса защитно-компенсаторных реакций, направленных на
ликвидацию последствий потери крови.
3. терминальную стадию, которая характеризуется нарастанием
патологических изменений, вплоть до смертельного исхода.
Развивается при недостаточности КПР, при обильной и быстрой
кровопотере, на фоне действия неблагоприятных факторов и при
отсутствии лечения.
23. КОМПЕНСАТОРНЫЕ РЕАКЦИИ ПРИ КРОВОПОТЕРЕ
В зависимости от сроков возникновения делятся насрочные и несрочные. Выделяют 4 механизма:
1.направленные на уменьшение сосудистого русла.
Цель -централизация кровообращения, для обеспечения
кровью жизненно важных органов.
2. направленные на увеличение ОЦК. Переход тканевой
жидкости в кровеносные сосуды, усиление реабсорбции
воды и ионов натрия в почках, действие катехоламинов
на сосуды печени, селезенки, подкожно-жировой
клетчатки.
24.
3. направленные на восстановление состава крови –обеспечиваются долговременными реакциями от
нескольких суток до 1-2 недель после кровотечения.
Большое значение имеет кислородное голодание почек,
из-за чего в кровь поступает большое количество
эритропоэтинов, в результате костный мозг регенерирует
молодые формы эритроцитов.
4.направленные на защиту от гипоксии –
обеспечиваются системой кровообращения (увеличение
МОК за счет увеличения силы и ЧСС, повышения АД,
перераспределения кровотока);
- системой крови (увеличение числа эритроцитов и
концентрации гемоглобина в периферической крови).
25. КЛИНИЧЕСКИЕ ПРОЯВЛЕНИЯ КРОВОПОТЕРИ
• 1. Кровообращение - нарушение системной гемодинамики(уменьшение ОЦК, падение АД) и местного кровообращения
(микроциркуляции) вплоть до развития шока.
• 2. Острая постгеморрагическая анемия.
• 3. Гипоксия, вначале циркуляторная, затем гемическая.
• 4. Негазовый ацидоз.(поступление молочной кислоты).
• 5. Нарушение экскреторной функции почек При падении АД
уменьшается клубочковая фильтрация и развиваются явления
почечной недостаточности: олиго и анурия, интоксикация (азотемия).
• 6. Геморрагический шок. Шок возникающий при острой кровопотери.
26. Патогенез геморрагического шока
Кровопотерягиповолемия
анемия
нарушение гемодинамики
гипоксия
ацидоз
острая почечная недостаточность
интоксикация
ЦНС и другие жизненно важные органы
смерть
27. ПАТОЛОГИЯ СИСТЕМЫ ЭРИТРОЦИТОВ
28.
29. ПАТОЛОГИЯ СИСТЕМЫ ЭРИТРОЦИТОВ
В норме количество эритроцитов:У мужчин - 4 – 5 х 1012
У женщин – 3,5 – 4,5 х 10
12
в 1 литре крови;
Концентрация гемоглобина:
У мужчин составляет 130-160 г/л
У женщин составляет 120-140 г/л
30. ПАТОЛОГИЯ СИСТЕМЫ ЭРИТРОЦИТОВ
Для облегчения диагностики анемии кроме стандартныханализов по определению гемоглобина, эритроцитов проводится
еще ряд дополнительных исследований:
• Средний объем эритроцита (MCV)
• Среднее содержание гемоглобина в эритроците (MCH)
• Средняя концентрация гемоглобина в эритроците (MCHC)
• Показатель распределения эритроцитов по объему (RDW)
• Цветовой показатель (ЦП)
31. ПАТОЛОГИЯ СИСТЕМЫ ЭРИТРОЦИТОВ
В условиях патологии возможны два вида изменений:Количества эритроцитов и гемоглобина в периферической крови
Качества эритроцитов и гемоглобина в периферической крови
32. КОЛИЧЕСТВЕННЫЕ ИЗМЕНЕНИЯ
1. Эритроцитоз – увеличение содержания эритроцитов свыше6 млн. в 1 литре и концентрации гемоглобина свыше 170 г/л.
Эритроцитоз подразделяют на:
- абсолютный ;
- относительный.
33. АБСОЛЮТНЫЙ ЭРИТРОЦИТОЗ
- Это повышение содержания эритроцитов и гемоглобинавследствие усиления эритропоэза.
• Приобретенный абсолютный эритроцитоз – возникает в
результате
увеличения
продукции
эритропоэтина
преимущественно в почках, что может быть вызвано:
А) нарушениями нейрогуморальной регуляции – возбуждением
симпатической части нервной системы, гиперфункцией ряда
эндокринных желез ( катехоламины, АКТГ, тиреоидные гормоны,
глюкокортикоиды усиливают утилизацию кислорода, что
способствует развитию гипоксии и образованию эритропоэтина).
Б) экзогенной, дыхательной , циркуляторной гипоксией – в случае
горной болезни, недостаточности внешнего дыхания и
кровообращения.
34. АБСОЛЮТНЫЙ ЭРИТРОЦИТОЗ
В) местной гипоксией почек вследствие их ишемии (гидронефроз,стеноз почечной артерии).
Г) гиперпродукция эритропоэтинов некоторыми опухолями
(гидронефрома, рак печени).
Абсолютный эритроцитоз развивается при истиной
полицитемии (эритремии), которая является разновидностью
хронического лейкоза.
35. АБСОЛЮТНЫЙ ЭРИТРОЦИТОЗ
• Наследственный абсолютный эритроцитоз – генетическиобусловленный дефект глобина или дефицит в эритроцитах 2,3 –
дифосфоглицерата, являющегося регулятором оксигенации и
дезоксигенации гемоглобина. При этом уменьшается отдача
кислорода
эритропоэз.
тканям.
Развивается
гипоксия,
стимулируется
36. ЗНАЧЕНИЕ АБСОЛЮТНОГО ЭРИТРОЦИТОЗА
Гипоксическое и дисциркуляторное состояние сопровождаетсяувеличением ОЦК, вязкости, замедлением скорости кровотока,
нарушением сердечной деятельности, повышением АД. В
результате - полнокровие внутренних органов, гиперемия кожи,
слизистых оболочек, усиление тромбообразования, а затем
кровоточивость (ДВС-синдром) .
37. ОТНОСИТЕЛЬНЫЙ ЭРИТРОЦИТОЗ
- Это увеличение содержания эритроцитов и гемоглобина вединице объема крови вследствие уменьшения объема плазмы.
Его развитие связано с действием факторов обуславливающих
обезвоживание организма или перераспределение крови,
вызывая полицитемическую гиповолемию (шок, ожог)
38. КОЛИЧЕСТВЕННЫЕ ИЗМЕНЕНИЯ
2. Анемия – это гематологический синдром или самостоятельноезаболевание, характеризующееся уменьшением количества
эритроцитов и /или содержания гемоглобина в единице объема
крови, а также качественными изменениями эритроцитов.
Гематологические признаки анемий разделяют на
количественные и качественные.
39. КОЛИЧЕСТВЕННЫЕ ИЗМЕНЕНИЯ
• К количественным признакам относятся:- Уменьшение содержания эритроцитов в крови у мужчин ниже 4
млн в литре, а у женщин ниже 3,5 .
- Уменьшение концентрации гемоглобина у мужчин ниже 130 г/л, а
у женщин ниже 120 г/л.
- Уменьшение гематокрита у мужчин ниже 43%, а у женщин ниже
40%.
- Изменение цветового показателя (норма 0,85 - 1).
40. КОЛИЧЕСТВЕННЫЕ ИЗМЕНЕНИЯ
• К качественным признакам относятся:- Регенераторные формы эритроцитов;
- Дегенеративные изменения в клетках эритроцитарного ряда;
- Клетки патологической регенерации
Общие клинические проявления анемий:
- гипоксия – синдром, возникающий при любом виде анемии
- синдромы, обусловленные особенностью патогенеза каждого
отдельного вида анемии (при В-12 –неврологические расстройства
и поражения пищеварительной системы, при гемолитической желтуха).
41. КАЧЕСТВЕННЫЕ ИЗМЕНЕНИЯ
1. Регенераторные формы – это молодые, незрелые клеткикрасного ростка крови, поступление которых в периферическую
кровь свидетельствует об усилении регенерации клеток
эритроидного ряда в красном костном мозге или увеличении
проницаемости косномозгового барьера.
К регенераторным формам относятся:
- ретикулоциты – безъядерные клетки «цвет болотной зелени»
с черными включениями в виде гранул. В номе их содержание от
0,2 – 2%. При усиленной регенерации их количество может
возрастать до 50%.
42. КАЧЕСТВЕННЫЕ ИЗМЕНЕНИЯ
- полихроматофилы – безъядерные эритроциты, цитоплазмакоторых воспринимает кислотные и основные красители.
По существу ретикулоциты и полихроматофилы являются клетками
одинаковой зрелости.
- нормобласты – ядерные предшественники эритроцитов. В
норме в периферической крови отсутствуют, содержатся только в
красном костном мозге.
43.
44. КАЧЕСТВЕННЫЕ ИЗМЕНЕНИЯ
2. Дегенеративные изменения – это качественные изменениясвидетельствующие
о
неполноценности
этих
клеток,
характеризующиеся :
- анизоцитозом – изменением величины эритроцитов. Возможно
появление макроцитов – диаметр которых свыше 8 мкм и
микроцитов – диаметр которых менее 6,5 мкм (норма 7,2 мкм).
- пойкилоцитозом – изменением формы (в норме двояковогнутый
диск). В условиях патологии могут появляться различные
изменения формы.
- анизохромией - изменением окраски эритроцитов, что зависит от
содержания
гемоглобина.
Различают
гиперхромные
и
гипохромные.
- наличием патологических включений – к ним относятся – тельца
Жолли, кольца Кебота, базофильная зернистость, которая
свидетельствует о токсическом поражении костного мозга.
45.
46.
47. КАЧЕСТВЕННЫЕ ИЗМЕНЕНИЯ
3. Клетки патологической регенерации – образуются приизменении типа кроветворения с эритробластического на
мегалобластический.
- мегалобласты – очень большие клетки диаметром 12-15 мкм с
базофильной, полихроматофильной или ацидофильной
цитоплазмой, содержащие крупное ядро.
- мегалоциты – безъядерные клетки, которые образуются при
созревании мегалобластов. Имеют диаметр 10-12 мкм и больше,
интенсивно окрашенные, овальной формы, без просветления в
центральной части.
48. АНЕМИИ. КЛАССИФИКАЦИЯ АНЕМИЙ
Патогенетическая классификация.• Постгеморрагические анемии
• Гемолитические анемии
• Анемии обусловленные нарушением эритропоэза
По регенераторной способности красного костного мозга
• Регенераторные (острая постгеморрагическая анемия)
• Гиперрегенераторные (приобретенная гемолитическая)
• Гипорегенераторные (железодефицитная)
• Арегенераторные (апластическая анемия)
49. АНЕМИИ. КЛАССИФИКАЦИЯ АНЕМИЙ
По этиологии• Наследственные и Приобретенные
По цветовому показателю
• Нормохромные (0,85 – 1)
• Гипохромные ( меньше 0,85)
• Гиперхромные (больше 1)
По клиническому течению
• Острые и Хронические
По типу кроветворения
• Анемии с эритробластическим типом кроветворения
• Анемии с мегалобластическим типом кроветворения
50. Постгеморрагическая анемия
- это анемия, которая развивается в результатекровопотери.
В зависимости от характера кровопотери
выделяют:
• - острую постгеморрагическую анемию
• - хроническую постгеморрагическую анемию
51. ОСТРАЯ ПОСТГЕМОРРАГИЧЕСКАЯ АНЕМИЯ
• - возникает после быстрой массивной кровопотери при ранениисосудов или их повреждении патологическим процессом.
Картина крови
Зависит от времени, прошедшего после кровотечения. С учетом
этого можно выделить три периода, характеризующиеся
определенной картиной периферической крови:
1. Первые часы после острой кровопотери – уменьшается общий
объем крови и количество эритроцитов, но гематокрит остается в
норме.
52. ОСТРАЯ ПОСТГЕМОРРАГИЧЕСКАЯ АНЕМИЯ
2. Период от нескольких часов до нескольких суток после остройкровопотери – уменьшение количества эритроцитов и
гемоглобина, снижается гематокрит, цветовой показатель остается
без изменений.
3. Период от нескольких суток до 1-2 недель после острой
кровопотери - появляется большое количество регенераторных
форм, что связано с усиленным эритропоэзом в красном костном
мозге. Поскольку молодые незрелые эритроциты содержат
гемоглобина меньше, то цветовой показатель уменьшается и
анемия становится гипохромной.
53. МОРФОЛОГИЯ ОСТРОЙ ПОСТГЕМОРРАГИЧЕСКОЙ АНЕМИИ
• Патологическая анатомия острой постгеморрагической анемииимеет следующий вид:
• Клетки костного мозга плоских и эпифизов трубчатых костей
усиленно пролиферируют, костный мозг становится сочным и
ярким.
• Жировой (желтый) костный мозг трубчатых костей также
становится красным, богатым клетками эритропоэтического и
миелоидного ряда.
• Появляются очаги внекостномозгового (экстрамедуллярного)
кроветворения в селезенке, лимфатических узлах, тимусе,
периваскулярной ткани, клетчатке ворот почек, слизистых и
серозных оболочках, коже.
54. ХРОНИЧЕСКАЯ ПОСТГЕМОРРАГИЧЕСКАЯ АНЕМИЯ
• Развивается вследствие повторных кровопотерь, вызванныхпоражением кровеносных сосудов при ряде заболеваний
(дисменорея, язвенная болезнь желудка, геморрой и др.)
• Потеря железа при частых кровотечениях придает этой анемии
железодефицитный характер.
Картина крови
Из-за потери железа развиваются признаки железодефицитной
анемии: уменьшение концентрации гемоглобина и цветового
показателя, в мазке крови появляются дегенеративные формы
эритроцитов – микро-, пойкилоцитоз, гипохромия. Количество
эритроцитов и гематокрит остаются без изменений.
55. хроническая постгеморрагическая анемия
56. МОРФОЛОГИЯ ХРОНИЧЕСКОЙ ПОСТГЕМОРРАГИЧЕСКОЙ АНЕМИИ
• При хронической постгеморрагической анемии кожные покровыи внутренние органы бледные.
• Костный мозг плоских костей обычного вида.
• В костном мозге трубчатых костей наблюдаются выраженные в
той или иной степени явления регенерации и превращение
жирового костного мозга в красный.
• Имеет место хроническая гипоксия тканей и органов, что
объясняет развитие жировой дистрофии миокарда, печени,
почек, дистрофические изменения в клетках головного мозга.
• Появляются множественные точечные кровоизлияния в серозных
и слизистых оболочках, во внутренних органах.
57. ГЕМОЛИТИЧЕСКАЯ АНЕМИЯ
• - Эта анемия возникает вследствие разрушения (гемолиза)эритроцитов.
По механизмам гемолиза анемии разделяют на:
- с внутрисосудистым гемолизом
- с внутриклеточным гемолизом
58. Гемолитическая анемия
Развитие гемолитической анемии может быть связано сдефектами эритроцитов:
• - дефекты мембраны (мембранопатии);
• - нарушением ферментов (ферментопатии);
• - изменение структуры гемоглобина (гемоглобинопатии).
Внутрисосудистый гемолиз возникает в кровеносных сосудах
под действием факторов повреждающих эритроциты –
гемолитические факторы. К ним относят:
• - физические (травма, ионизирующая радиация, ультразвук,
температура);
• - химические (гемолитические яды);
• - биологические и иммунные (возбудители инфекционных
заболеваний, токсины и ферменты бактерий, антитела).
59. ГЕМОЛИТИЧЕСКАЯ АНЕМИЯ
• Механизмы внутрисосудистого гемолиза:1.Механический гемолиз
2. Осмотический гемолиз
3.Окислительный гемолиз
4. Детергентный гемолиз
5. Комплементзависимый гемолиз
60.
61. электронная микроскопия гемолиза
62. ГЕМОЛИТИЧЕСКАЯ АНЕМИЯ
Внутриклеточный гемолиз –развивается вследствиепоглощения и переваривания эритроцитов макрофагами.
• Причины:
• - появление дефектных эритроцитов. Уменьшение
пластичности, способности к деформации, отек – не позволяют
им проходить через межэндотелиальные щели венозных синусов
селезенки и надолго задерживаются в красной пульпе, где
контактируют с макрофагами.
• - появление на мембранах эритроцитов химических групп,
которые взаимодействуют с рецепторами макрофагов.
• - гиперспленизм – увеличение фагоцитарной активности
макрофагов селезенки
63. ГЕМОЛИТИЧЕСКАЯ АНЕМИЯ
Усиленный фагоцитоз эритроцитов макрофагами вызывает:• - образование и выделение макрофагами эритропоэтинов, в
результате усиливается эритропоэз и в крови повышается уровень
регенераторных форм эритроцитов в периферической крови.
• - образование большого количества
обуславливает развитие желтухи
билирубина,
что
• - пролиферацию макрофагов, которая приводит к увеличению
селезенки.
64. ПРИОБРЕТЕННАЯ ГЕМОЛИТИЧЕСКАЯ АНЕМИЯ
• Виды:1. Анемии обусловленные механическим повреждением
эритроцитов. (повреждение при протезировании сосудов или
клапанов
сердца,
маршевая
гемоглобинурия,
микроангиопатическая гемолитическая анемия при ДВС –
синдроме при столкновении эритроцитов с нитями фибрина).
2. Иммунные гемолитические анемии – возникают при участии
специфических
иммунных
механизмах.
Происходит
взаимодействие
гуморальных
антител
с
антигенами,
фиксированными на мембране эритроцитов и поэтому являются
проявлением аллергических реакций второго типа по Кумбсу.
65. ПРИОБРЕТЕННАЯ ГЕМОЛИТИЧЕСКАЯ АНЕМИЯ
Причиной является поступление антител извне (гемолитическаяболезнь новорожденных, при которой происходит гемолиз
эритроцитов плода и новорожденного, вызванного антителами
матери). Чаще встречаются варианты резус-конфликт и АВОконфликт.
3. Токсические гемолитические анемии. Связаны с химическими
агентами (мышъяковистый водород, свинец, соли меди, резорцин,
фенилгидразин), а также желчными кислотами, продуктами
образующимися при ожоговой болезни, уремии, ядами пауков,
пчел, змей.
66.
67. ПРИОБРЕТЕННАЯ ГЕМОЛИТИЧЕСКАЯ АНЕМИЯ
4. Инфекционные гемолитические анемии. Вызываютинфекционные агенты(гемолитический стрептококк,
малярийный плазмодий, токсоплазма, лейшмании).
Причина гемолиза связана с размножением возбудителя,
либо действием токсинов-гемолизинов.
5. Приобретенные мембранопатии. Возникают в
процессе развития дефектов мембран эритроцитов
(пароксизмальная ночная гемоглобинурия, так как в
ночное время уменьшается рН, то происходит разрушение
эритроцитов).
68. ПРИОБРЕТЕННАЯ ГЕМОЛИТИЧЕСКАЯ АНЕМИЯ
Картина кровиУменьшается количество эритроцитов и гемоглобина, но при
внутрисосудистом гемолизе его содержание может не изменятся,
за счет гемоглобина в плазме крови. Цветовой показатель в норме,
но может быть больше – 1. В мазке крови – большое количество
регенераторных форм. Что свидетельствует о регенеративном и
гиперрегенеративном характере анемии.
69. мазок крови при гемолитической анемии
70. НАСЛЕДСТВЕННАЯ ГЕМОЛИТИЧЕСКАЯ АНЕМИЯ
В зависимости от механизмов развития их подразделяют :1. Мембранопатии.
2. Ферментопатии.
3. Гемоглобинопатии.
71. НАСЛЕДСТВЕННАЯ ГЕМОЛИТИЧЕСКАЯ АНЕМИЯ
• Мембранопатии.• Наследственные могут быть обусловлены нарушением
мембранных белков и липидов. В результате нарушения работы
натриево-калиевого насоса, в эритроциты усиленно поступает
вода и они приобретают форму сферы. (болезнь МинковскогоШоффара).
• Увеличенные эритроциты теряют способность к деформации и не
могут пройти селезеночный фильтр, задерживаясь в ней.
Макрофаги «откусывают» часть мембраны эритроцита и
превращают их в микросфероциты.
• Последние
поглощаются
макрофагами
и
происходит
внутриклеточный гемолиз. Срок жизни укорачивается до 8 – 12
дней. Как лечение назначается спленэктомия.
72. НАСЛЕДСТВЕННАЯ ГЕМОЛИТИЧЕСКАЯ АНЕМИЯ
• Ферментопатии. Связаны с нарушениемферментных систем эритроцитов. Эти нарушения
приводят к увеличению поступления натрия в
клетку и соответственно воды, что в итоге
заканчивается гемолизом.
73. НАСЛЕДСТВЕННАЯ ГЕМОЛИТИЧЕСКАЯ АНЕМИЯ
• Гемоглобинопатии. Качественные связаны с нарушениемпервичной структуры цепей гемоглобина (замена аминокислот,
удлинение или укорочение цепей молекул).Например,
серповидноклеточная анемия при которой дефект связан с
заменой глутамина на валин. Это приводит к появлению
патологической формы гемоглобина, которую обозначают как
HbS. Такой гемоглобин теряет растворимость в 100 раз и
выпадает в осадок, образуя кристаллы, которые приводят к
деформации эритроциты и они приобретают серповидную
форму.
• Такие эритроциты также задерживаются в селезенке, что
объясняет их активный гемолиз, а также приводит к трофическим
изменениям в тканях до микротромбозов и некрозов.
74. мазок крови при серповидноклеточной анемии
75. НАСЛЕДСТВЕННАЯ ГЕМОЛИТИЧЕСКАЯ АНЕМИЯ
• Количественные гемоглобинопатии связаны с нарушениемсинтеза цепей гемоглобина. Примером является талассемия. Если
нарушается синтез альфа-цепей, то развивается альфаталассемия, при которой эритроциты вместо альфа цепей
синтезируют бета- и гамма-цепи. При бета-талассемии
нарушается синтез бета-цепей и т.д. Появляются патологичные
формы гемоглобина, они не стабильны и легко выпадают в
осадок при этом эритроциты имеют вид мишеневидных.
Измененные эритроциты фагоцитируются и развивается
внутриклеточный гемолиз.
76. мазок крови при талассемии
77. ГЕМОЛИТИЧЕСКИЕ АНЕМИИ
• Картина крови• резкое увеличение числа ретикулоцитов вплоть до случаев, когда
почти все эритроциты могут оказаться ретикулоцитами.
• Морфологические
изменения
эритроцитов.
Некоторые
гемолитические анемии содержать эритроциты "своей"
специфической формы: серповидноклеточная анемия серповидные эритроциты; талассемия - мишеневидные
эритроциты. Диаметр части зрелых эритроцитов уменьшен из-за
их сферичности, размеры ретикулоцитов и нормоцитов находятся
в норме. При некоторых гемолитических анемиях ярко выражен
анизоцитоз.
• Нейтрофильный лейкоцитоз со сдвигом влево.
78. МОРФОЛОГИЯ ГЕМОЛИТИЧЕСКОЙ АНЕМИИ
Патологоанатомическая картина выглядит следующим образом:• Возникают общий гемосидероз и надпеченочная желтуха, а
также гемоглобинурийный нефроз.
• Костный мозг гиперплазирован, розово-красного цвета, сочный.
• В селезенке, лимфатических узлах, рыхлой соединительной ткани
возникают очаги экстрамедулярного кроветворения.
79. КЛИНИЧЕСКИЕ ПРОЯВЛЕНИЯ ГЕМОЛИТИЧЕСКИХ АНЕМИЙ
• Гипоксия. Обусловлена анемией и проявляется резкой слабостьюи неприятными ощущениями в области сердца, сердцебиением,
одышкой.
• Гемолитическая желтуха. Связана с гемолизом и повышенным
образованием билирубина в клетках системы мононуклеарных
фагоцитов (в печени).
• Повышением
уровня
стеркобилиногена
в
моче
и
кале(гиперхоличный кал).
• Повышение уробилиногена в моче.
• Усиленное образование желчных камней из-за увеличения
вязкости желчи.
80. КЛИНИЧЕСКИЕ ПРОЯВЛЕНИЯ ГЕМОЛИТИЧЕСКИХ АНЕМИЙ
• Гемоглобинурия. Развивается при внутрисосудистом гемолизе.Если концентрация гемоглобина в плазме превышает 125 мг %, то
несвязанный гемоглобин проходит почечный барьер и
появляется в моче. (в норме белок плазмы гаптоглобин может
связать только 125 мг % гемоглобина ).
• Спленомегалия. При внутриклеточном гемолизе. Часто
сопровождается гепатомегалией из-за пролиферации печеночных
макрофагов.
• Гемосидероз.
• Нарушение микроциркуляции с развитием ДВС-синдрома.
• Лихорадка. Связана с высокой фагоцитарной активностью и
выделением макрофагами Ил-1.
81. АНЕМИИ СВЯЗАННЫЕ С НАРУШЕНИЕМ ЭРИТРОПОЭЗА
• По этиологии выделяют:- Миелотоксические
- Дефицитные
- Дисрегуляторные
- Связанные с уменьшением кроветворной ткани.
• По патогенезу :
- Нарушение образования эритроцитов
- Нарушение синтеза гемоглобина
82. ГИПОПЛАСТИЧЕСКАЯ АНЕМИЯ
- или апластическая , характеризуется угнетениемкроветворной функции красного костного мозга и проявляется
недостаточностью образования эритроцитов, гранулоцитов и
тромбоцитов или одних эритроцитов.
• Приобретенные формы связаны с причинами:
- биологическими – вирус гепатита
- физическими – ионизирующая радиация
- химическими – бензол, свинец, пары ртути, лекарственные
препараты (цитостатики, левомицетин, сульфаниламиды)
- идиопатическая 50-75 % всех случаев.
83. ГИПОПЛАСТИЧЕСКАЯ АНЕМИЯ
Все причины разделяются на факторы с облигатныммиелотоксическим эффектом и факторы с факультативным
миелотоксическим эффектом, который может проявляться в
отдельных единичных случаях.
Ведущее место в патогенезе занимают два механизма:
- повреждение стволовых клеток
- нарушение стромальных клеток, оказывающих влияние на
созревание клеток.
84. ГИПОПЛАСТИЧЕСКАЯ АНЕМИЯ
• Картина крови• резко выраженное уменьшение концентрации гемоглобина;
• выраженное уменьшение количества эритроцитов;
• цветовой показатель в норме - нормохромная анемия;
• увеличение среднего размера эритроцитов - макроцитарная
анемия;
• снижения содержания (до полного исчезновения) ретикулоцитов снижено-выраженная гипорегенараторность (арегенераторность);
• нормобластический тип кроветворения;
• СОЭ повышена;
• число
лейкоцитов
и
тромбоцитов
не
изменяется
(парциальноклеточная
анемия),
либо
уменьшается
(тотальноклеточная
анемия).
Лейкопения
обусловлена
гранулоцитопенией.
85. МОРФОЛОГИЯ ГИПО- И АПЛАСТИЧЕСКОЙ АНЕМИИ
Гипо– и апластические анемии являются следствием глубокогоизменения кроветворения, особенно молодых элементов гемопоэза.
Происходит угнетение вплоть до подавления гемопоэза:
• Если происходит лишь угнетение, то в пунктате из грудины можно
найти молодые клеточные формы эритро– и миелопоэтического ряда.
• При подавлении гемопоэза костный мозг опустошается и замещается
жировым мозгом, таким образом развивается панмиелофтиз.
Возникают множественные кровоизлияния в слизистых и серозных
оболочках,
явления общего гемосидероза,
жировая дистрофия миокарда, печени, почек,
язвенно-некротические процессы в желудочно-кишечном тракте.
86. мазок крови при гипо- и аплатической анемии
87. КЛИНИЧЕСКИЕ ПРОЯВЛЕНИЯ ГИПОПЛАСТИЧЕСКОЙ АНЕМИИ
Все симптомы гипо- и апластических анемий объединены в 3синдрома.
Анемический синдром: слабость, снижение работоспособности,
головокружение, обморочные состояния, шум в ушах, мелькание
«мушек» перед глазами, одышка и сердцебиение при
незначительной физической нагрузке, колющие боли в грудной
клетке.
Геморрагический синдром: развивается при снижении
количества тромбоцитов и при их неполноценности. Проявления:
кровоизлияния на коже и слизистых оболочках, носовые
кровотечения, кровотечения из десен, почечные и другие
кровотечения, кровоизлияния в головной мозг (редко).
88. КЛИНИЧЕСКИЕ ПРОЯВЛЕНИЯ ГИПОПЛАСТИЧЕСКОЙ АНЕМИИ
Синдром инфекционных осложнений развивается приснижении количества лейкоцитов: инфекции кожи, инфекции
дыхательных путей, инфекции мочевыводящих путей и др..
89. МЕГАЛОБЛАСТИЧЕСКАЯ АНЕМИЯ
- это анемия, в основе патогенеза которой лежит нарушениесинтеза нуклеиновых кислот в клетках, вследствие чего нарушается
размножение последних.
• К таким анемиям относится анемия обусловленная дефицитом
витамина В -12 и фолиевой кислоты.
• Витамин В-12 – цианкобаламин, поступает в организм с
животными белками в связанном виде. В результате гидролиза
белков в желудке витамин высвобождается и образует комплекс
с гастромукопротеином (внутренний фактор
Кастла).
Образовавшийся комплекс всасывается в среднем и нижнем
отделах подвздошной кишки.
90. МЕГАЛОБЛАСТНАЯ АНЕМИЯ
• Транспортируется в крови с помощью белка транскобаламина.• Печень является депо В-12, его запасы могут не пополнятся в
течении 3-6 лет.
• В клетках из В-12 образуются две коферментные формы –
метилкобаламин и 5-дезоксиаденозилкобаламин
• Метилкобаламин необходим для синтеза ДНК клеток, поэтому
влияет на кроветворение, участвует в превращении фолиевой
кислоты в продукты идущие на построение ДНК клеток. Его
дефицит приводит к нарушению образования пуриновых
оснований, нарушается синтез ДНК и размножение клеток в
первую очередь кроветворных и эпителия пищеварительного
канала.
91. МЕГАЛОБЛАСТНАЯ АНЕМИЯ
• 5- дезоксиаденозилкобаламин необходим для нормальногообмена жирных кислот и принимает участие в обезвреживании
токсичных кислот превращая их в янтарную. В результате
недостаточности накапливаются токсичные для нервных клеток –
метилмалоновая и пропионовая кислоты. Кроме того в нервных
волокнах синтезируются жирные кислоты с измененной
структурой, что приводит к нарушению образования миелина и
повреждению аксонов. Развивается дегенерация задних и
боковых столбов спинного мозга, поражаются черепные и
периферические нервы.
92. МЕГАЛОБЛАСТНАЯ АНЕМИЯ
• Причины :• 1. алиментарная недостаточность (в основном у детей
вскормленных смесями).
• 2. нарушение всасывания витамина В-12:
- нарушение секреции и образования гастромукопротеина из-за
наследственной патологии, атрофии слизистой оболочки желудка,
аутоимунными повреждениями париетальных клеток слизистой
желудка, после гастроэктомии или удалении более 2/3 желудка.
- нарушении функций тонкой кишки (хронические поносы –
целиакия, спру; резекция больших участков кишки).
- гельминтозы и нарушенная микрофлора кишки.
93. МЕГАЛОБЛАСТНАЯ АНЕМИЯ
• 3. нарушение образования в печени транкобаламина.• 4. нарушение депонирования В-12 в печени (при циррозе).
• 5. усиленное использование В-12 (при беременности).
В
красном
костном
мозге
эритробластический
тип
кроветворения сменяется мегалобластическим, возрастает
неэффективный эритропоэз, укорачивается жизнь эритроцитов и
развивается анемия, при которой клетки патологической
регенерации и эритроциты с дегенеративными сдвигами
появляются не только в костном мозге, но и в периферической
крови.
94. МЕГАЛОБЛАСТНАЯ АНЕМИЯ
• Изменения в клетках миелоидного мегакариоцитарного рядапроявляются
уменьшением
количества
лейкоцитов
и
тромбоцитов, выраженной атипией клеток (гигантские
нейтрофилы, мегакариоциты с изменениями в ядре).
• Возникновение атипичных митозов и гигантских клеток эпителия
пищеварительного канала приводит к развитию воспалительных
и атрофических процессов в слизистой оболочке его отделов.
Развиваются – глоссит, стоматит, ахилический гастрит, энтерит.
• Это усугубляет первичное нарушение секреции или всасывание
гастромукопротеина и усиливает дефицит В-12.
95. МЕГАЛОБЛАСТНАЯ АНЕМИЯ
• Картина крови• В крови и красном костном мозге появляются мегалобласты и
мегалоциты.
• Уменьшается количество эритроцитов и гемоглобина, при этом
цветовой показатель увеличен (из-за большого размера
эритроцитов).
• Анизоцитоз (макроциты), пойкилоцитоз (овалоциты),
патологические включения (тельца Жолли, кольца Кебота).
• Уменьшается количество гранулоцитов и тромбоцитов
96. МОРФОЛОГИЯ МЕГАЛОБЛАСТНОЙ АНЕМИИ
• Костный мозг плоских костей малиново-красный, сочный.• В трубчатых костях костный мозг имеет вид малинового желе.
• В гиперплазированном костном мозге преобладают незрелые
формы эритропоэза – эритробласты, которые находятся и в
периферической крови.
• В спинном мозге визуализируется распад миелина и осевых
цилиндров.
• Иногда в спинном мозге появляются очаги ишемии и
размягчения.
97. МОРФОЛОГИЯ МЕГАЛОБЛАСТНОЙ АНЕМИИ
• Кожные покровы при этом бледные с лимонно-желтым оттенком,склеры желтые.
• На коже, слизистых и серозных оболочках образуются
кровоизлияния.
• Отмечается гемосидероз внутренних органов, особенно
селезенки, печени, почек.
• Слизистая желудка истончена, склерозирована, гладкая и лишена
складок. Железы уменьшены, атрофия эпителия, сохранны лишь
главные клетки.
• Лимфоидные фолликулы атрофичны.
• В слизистой кишечника также присутствуют атрофические
процессы.
98. мазок крови при мегалобластной анемии
99. мазок крови при мегалобластной анемии
100. КЛИНИЧЕСКИЕ ПРОЯВЛЕНИЯ МЕГАЛОБЛАСТНОЙ АНЕМИИ
• Гематологические синдромы( анемия и гипоксия).• Лейкопения (нейтропения) приводит к снижению резистентности
организма к инфекциям
• Тромбоцитопения
синдрома
вызывает
развитие
геморрагического
• Поражение пищеварительного канала
• Поражения центральной и периферической нервной системы.
101. ЖЕЛЕЗОДЕФИЦИТНАЯ АНЕМИЯ
• может быть вызвана формированием отрицательного баланса пожелезу, что приводит к истощению его запасов, либо нарушением
метаболизма железа внутри организма.
• Одна из наиболее часто встречающихся анемий .
• Железо поступает в организм с пищей. Всасывается в виде гемма
в кишечнике. Стенки кишок содержат фермент гемоксигеназу,
расщепляющий гем пищевых продуктов на билирубин, оксид
углерода(2) и ионы железа. Этому способствует аскорбиновая
кислота, фруктоза, пировиноградная кислота.
• В сутки всасывается 2,5 мг железа, независимо от потребности
организма.
102. ЖЕЛЕЗОДЕФИЦИТНАЯ АНЕМИЯ
• Транспортируется в виде белка трансферрина, а депонируется ввиде ферритина.
• Поступая в клетки, железо связывается с внутриклеточным
белком сидерохилином. Который транспортирует железо в
митохондрии, где синтезируется гем.
• Физиологические потери железа у мужчин менее 1 мг/сут. (с
мочой, потом, слущенным эпителием кожи), у женщин потери
больше и они связаны с физиологическими особенностями.
103. ЖЕЛЕЗОДЕФИЦИТНАЯ АНЕМИЯ
Причины:• 1. недостаточное поступление железа в организм:
- алиментарная анемия у грудных детей
- нарушение всасывания железа в пищеварительном тракте
(резекция желудка, кишок, гастриты, энтериты).
• 2. кровопотери – наиболее распространенная причина дефицита
железа в организме, чаще из-за повторяющихся кровотечений.
• 3. усиленное использование железа (лактация, беременность).
104. ЖЕЛЕЗОДЕФИЦИТНАЯ АНЕМИЯ
Патогенез:• 1. дефицит железа – нарушение синтеза гема и
гемоглобина – анемия.
• 2. дефицит железа – нарушение синтеза гема –
нарушение образования цитохрома – расстройство –
расстройство клеточного дыхания - тканевая гипоксия.
105. ЖЕЛЕЗОДЕФИЦИТНАЯ АНЕМИЯ
• 3. дефицит железа – нарушение синтеза гема –нарушение функций антиоксидантных систем –
активация СПОЛ – повреждение клеток- гемолиз
эритроцитов и развитие дистрофических изменений в
клетках
• 4. дефицит железа – нарушение синтеза гема –
уменьшение
синтеза
миоглобина
–
снижение
приспособительных возможностей клеток к гипоксии.
106. ЖЕЛЕЗОДЕФИЦИТНАЯ АНЕМИЯ
• Картина крови• Снижение концентрации гемоглобина в периферической крови и
уменьшение цветового показателя.
• Количество эритроцитов может быть в норме или уменьшаться.
• В мазке уменьшено количество регенераторных форм,
анизоцитоз (микроцитоз), пойкилоцитоз, дегенеративные формы.
• В биохимическом анализе отмечается снижение содержания
железа в сыворотке крови и степени насыщения трансферрина
железом.
107. мазок крови при железодефицитной анеми
108. КЛИНИЧЕСКИЕ ПРОЯВЛЕНИЯ ЖЕЛЕЗОДЕФИЦИТНОЙ АНЕМИИ
• 1. гематологический синдром (анемия и гипоксия). Приусловиях дефицита железа развивается гемическая и
тканевая гипоксии, что проявляется общей слабостью,
головокружением, одышкой, обмороками.
• 2. синдром трофических нарушений – сухость и трещины
кожи, заеды, ангулярный стоматит, поражение ногтей,
атрофия сосочков языка, атрофия слизистой желудка.
109. КЛИНИЧЕСКИЕ ПРОЯВЛЕНИЯ ЖЕЛЕЗОДЕФИЦИТНОЙ АНЕМИИ
• 3. сидеропенический синдром – извращение вкуса иобоняния (едят мел, зубной порошок, уголь, песок, глину,
сырой мясной фарш, сырые крупы, лед, имеют
пристрастие к запахам керосина, бензина, ацетона,
выхлопных газов и т.д.).
• 4. синдром мышечной слабости – снижение образования
миоглобина приводит к развитию значительной слабости
и утомляемости скелетной мускулатуры, слабости
миокарда (миокардиопатия), нарушению глотания
(дисфагия), нарушению мочеиспускания.
110. ПАТОЛОГИЯ СИСТЕМЫ ЛЕЙКОЦИТОВ
111. СИСТЕМА ЛЕЙКОЦИТОВ
• Общее количество лейкоцитов (норма - 4,0-9,0·109/л) - этоабсолютное содержание лейкоцитов в единице объема крови.
• При заборе капиллярной крови из пальца определяется число
лейкоцитов, вовлеченных в циркуляцию крови (циркуляционный
пул).
• В кровеносном русле часть лейкоцитов располагается
пристеночно, образуя маргинальный пул, и не участвуя в общей
циркуляции.
• Количество лейкоцитов в циркуляционном и маргинальном пулах
приблизительно равно.
112. СИСТЕМА ЛЕЙКОЦИТОВ
• Количество лейкоцитов зависит не только от наличияпатологического процесса, но, также и от физиологического
состояния организма, возраста, времени суток, физического и
эмоционального напряжения, беременности, болевых ощущений
и т.д.
• Лейкоциты содержатся в организме:
- В красном костном мозге - 500г
- Периферической крови – 10г
- Периферические ткани – 600г
113. СИСТЕМА ЛЕЙКОЦИТОВ
114. СИСТЕМА ЛЕЙКОЦИТОВ
Основные функции лейкоцитов:• Выходят в желудочно-кишечный тракт, захватывают питательные
вещества и переносят их в кровь, что в особенности важно для
новорожденных, которые, находясь на грудном вскармливании,
вместе с молоком получают готовые неизмененные
иммуноглобулины матери, способные защитить от многих
инфекций маленького человека.
• Лейкоциты принимают участие в формировании клеточного и
гуморального иммунитета, что составляет их защитную функцию.
115. СИСТЕМА ЛЕЙКОЦИТОВ
• Растворяютповрежденные
гистолитическую задачу.
ткани
и
осуществляют
• Лейкоциты снабжают регенерирующие ткани питательными
веществами и стимуляторами деления клеток.
• Гранулоциты участвуют в развитии сосудистых нарушений, как
переносчики вазоактивных веществ (базофилы, эозинофилы) или
влияют на их синтез и освобождение из тканевых базофилов
(нейтрофильные).
116. ПАТОЛОГИЯ СИСТЕМЫ ЛЕЙКОЦИТОВ
Патология проявляется:- нарушением образования в кроветворной ткани.
- количественные и качественные сдвиги лейкоцитов
крови.
117. ПАТОЛОГИЯ СИСТЕМЫ ЛЕЙКОЦИТОВ
Эти изменения могут быть следствием :• первичного поражения клеток гранулоцитарного,
лимфоцитарного, моноцитарного ряда при нарушении их
образования, созревания, разрушения в кроветворной
ткани, кровеносном русле под влиянием патогенных
факторов.
• Вторичных изменений возникающих как ответная
реакция организма, часто защитная, и патологические
изменения связаны не с системой крови, а с другими
органами и системами.
118. ПАТОЛОГИЯ СИСТЕМЫ КРОВИ
Главным в патогенезе нарушений является изменениереактивности
организма,
что
связано
с
функциональными особенностями лейкоцитов (участие
в фагоцитозе, антител образовании, инактивации БАВ –
серотонина, гистамина и брадикинина).
патологические
сопровождаться:
изменения
лейкоцитов
- трофическими нарушениями тканей.
- местными микроциркуляторными расстройствами
могут
119. ПАТОЛОГИЯ СИСТЕМЫ ЛЕЙКОЦИТОВ
Для характеристики состояния системы лейкоцитовиспользуют показатели:
• Лейкоцитоз – увеличение содержания лейкоцитов более
9 Х 109 в 1 литре периферической крови.
• Лейкопения – уменьшение содержания лейкоцитов
менее 4 Х 109 в 1 литре периферической крови.
120. ЛЕЙКОПЕНИИ
Различают лейкопении первичные (наследственные) ивторичные (приобретенные).
Первичные лейкопении (в большинстве случаев это
нейтропении) различные заболевания такие как болезнь
Костмана, Шедьяка (Чедиака) – Хегаси («ленивые
лейкоциты»), врожденная алейкия и др.
121. ЛЕЙКОПЕНИИ
Вторичные лейкопении возникают:• при воздействии ионизирующей радиации, бензола,
горчичного газа, инсектицидов, лекарственных веществ
(НВПС, атиметаболиты, сульфаниламиды, алкилирующие
вещества, противоопухолевые препараты.),
• при
развитии
аутоиммунных
генерализованных
инфекций
риккетсиозы, корь, грипп и др.)
болезней
(брюшной
(СКВ),
тиф,
122. ЛЕЙКОПЕНИИ
Развитие лейкопений является результатом:• нарушения и/или угнетения процесса лейкопоэза;
• чрезмерного разрушения лейкоцитов в сосудистом русле
и органах гемопоэза (АТ);
123. ЛЕЙКОПЕНИИ
• при перераспределении в сосудистом русле (шок,тяжелая мышечная работа, воспаление);
• потери лейкоцитов (острая и хроническая кровопотеря);
• Гемодилюции (гиперволемия при избыточном введении
плазмы).
124. ЛЕЙКОПЕНИИ
Проявление лейкопении:• Снижение содержания в единице объема крови
лейкоцитов всех видов или одного из них:
лимфоцитопения,
моноцитопения,
нейтропения,
эозинопения.
• Уменьшение молодых форм нейтрофилов на начальных
этапах развития лейкопенической реакции, что
свидетельствует
об
угнетении
регенераторной
способности кроветворной ткани.
• Признаки дегенерации выявляются чаще в моноцитах и
нейтрофилах (пойкилоцитоз, анизоцитоз, токсическая
зернистость, гиперсегментация, кариорексис ядер.)
125. ЛЕЙКОПЕНИИ
• Дегенеративные лейкоциты при лейкопении в сочетаниис уменьшение числа сегментоядерных нейтрофилов и
умеренным увеличением палочкоядерных обозначается
как дегенеративный ядерный сдвиг влево.
• Если увеличивается число сегментоядерных лейкоцитов с
признаками дегенеративных изменений в них без
увеличения числа палочкоядерных клеток, то говорят о
ядерном сдвиге вправо
126. ЗНАЧЕНИЕ ЛЕЙКОПЕНИИ
При выраженной лейкопении наблюдается снижениерезистентности организма (противоинфекционной и
противоопухолевой).
Это обусловлено тем, что лейкоциты участвуют в
реализации клеточного и гуморального иммунитета, а
также фагоцитарной активности.
Поэтому
при
лейкопении
инфицирование
организма
новообразований.
часто
наблюдается
и
развитие
127. АГРАНУЛОЦИТОЗ
- это клинико-диагностический синдром, характеризующийсяуменьшением содержания нейтрофилов ниже 0,75 х 109 / л при
уменьшении общего количества лейкоцитов ниже 1 х 109 /л. В
основе развития агранулоцитоза могут лежать два механизма:
• Миелотоксический – поражение красного костного мозга;
• Иммунный – разрушение клеток гранулоцитарного ряда
антилейкоцитарными антителами.
Агранулоцитоз сопровождается ослаблением реактивности
организма в связи с выключением защитной функции
лейкоцитов, повышается восприимчивость организма к
бактериальным и грибковым инфекциям.
128. ЛЕЙКОЦИТОЗ
Лейкоцитоз не имеет самостоятельного значения, аявляется
симптомом,
сопровождающим
многие
заболевания.
В зависимости от причины выделяют:
• Физиологический
• Патологический
В зависимости от патогенеза:
• Абсолютный
• Относительный
129. ЛЕЙКОЦИТОЗ
Механизмы развития лейкоцитоза:- Усиление лейкопоэза (воспаление, аллергия) такие лейкоцитозы
обозначают как истинные или абсолютные (регенераторные).
- Перераспределение в сосудистом русле (шок, физ. нагрузка),
носит временный характер без увеличения молодых форм,
поэтому такие лейкоцитозы называют ложными.
- Повышенное
образование
при
(пролиферация лейкозных клеток).
опухолевом
процессе
- Гемоконцентрация (гипогидротация с развитием гиповолемии).
130. ЛЕЙКОЦИТОЗ
Физиологический лейкоцитоз связан с такими факторами:• Курение.
• Стрессы, серьезные эмоциональные переживания.
• Рацион питания. Некоторые продукты могут влиять на лейкоциты.
• Во второй половине беременности.
• Спорт и физические нагрузки.
• Пребывание в условиях горячего воздуха (солнечные ванны,
рабочая обстановка, бани и сауны).
131. ЛЕЙКОЦИТОЗ
Патологический лейкоцитоз вызывают:• инфекционные заболевания: пневмония, отит, рожа, менингит и
т.д.;
• воспалительные процессы: плеврит, панкреатит, аппендицит,
перитонит, абсцесс, флегмона и т.д.;
• большие ожоги;
• инфаркт сердца, легких, селезенки, почек;
• тяжелые кровопотери;
• лейкозы;
132. ЛЕЙКОЦИТОЗ
• хроническая почечная недостаточность;• диабетическая кома.
• Аутоиммунные заболевания, типичным проявлением которых
является распознавание иммунной системой собственных тканей,
как чужеродных, и формирование ответа организма.
При ослабленном иммунитете лейкоцитоз может не
наблюдаться при инфекционных и воспалительных процессах, что
является неблагоприятным признаком.
133. ЛЕЙКОЦИТОЗ
Абсолютныйлейкоцитоз
сопровождается
увеличением абсолютного количества лейкоцитов в
единице объема крови.
Относительный
лейкоцитоз
сопровождается
относительным увеличением содержания отдельных
форм лейкоцитов в периферической крови.
134. ЛЕЙКОЦИТОЗ
В зависимости от вида лейкоцитов различают:• нейтрофильный
лейкоцитоз
–
при
гнойновоспалительных процессах, вызванных гноеродной
флорой (абсцессы, флегмоны, сепсис), при кислородном
голодании (при кровопотери, остром гемолизе),
эндогенной интоксикации (уремия).
• эозинофильный лейкоцитоз – при аллергических
реакциях первого типа, гельминтозах, хроническом
миелолейкозе.
135. ЛЕЙКОЦИТОЗ
• базофильный лейкоцитоз – редко, при хроническоммиелолейкозе, гемофилии, полицитемии.
• лимфоцитарный лейкоцитоз – при острых инфекционных
заболеваниях (коклюш, вирусный гепатит), некоторые
хронические инфекционные болезни (туберкулез, сифилис,
бруцеллез), хронический лимфолейкоз.
• моноцитарный
лейкоцитоз
–
при
хронических
инфекционных заболеваниях, инфекционном мононуклеозе,
при инфекциях вызванных риккетсиозами и простейшими
(сыпной тиф , малярия).
136. ЛЕЙКОЦИТАРНАЯ ФОРМУЛА
Лейкоцитарная формула - это соотношение в кровиразличных форм лейкоцитов, выраженное в
процентах.
137. ЛЕЙКОЦИТАРНАЯ ФОРМУЛА
138. ЛЕЙКОЦИТАРНАЯ ФОРМУЛА
• Патологические состояния в организме проявляютсяизменениями лейкоцитарной формулы. Это обозначается
как «сдвиг лейкоцитарной формулы».
• Выделяют:
- сдвиг влево
- сдвиг вправо
139. ЛЕЙКОЦИТАРНАЯ ФОРМУЛА
Изменение лейкограммы с увеличением процентногосодержания молодых форм нейтрофилов называется
сдвигом влево.
Увеличение процентного содержания за счет
сегментоядерных и полисегментоядерных форм
называется сдвигом вправо.
140. ЛЕЙКОЦИТАРНАЯ ФОРМУЛА
Выраженность сдвига ядер нейтрофилов оцениваетсяиндексом сдвига (ИС в норме равен 0,06), который является
важным диагностическим критерием, определяющим
тяжесть течения острой инфекции и общий прогноз:
ИС = (М + ММ + П) / С
где
М - миелоциты;
ММ - метамиелоциты;
П - палочкоядерные нейтрофилы;
С - сегментоядерные нейтрофилы.
141. ЛЕЙКОЦИТАРНАЯ ФОРМУЛА
Сдвиг лейкоцитарной формулы влево (в крови присутствуютметамиелоциты, миелоциты):
• острые воспалительные процессы;
• гнойные инфекции;
• интоксикации;
• острые геморрагии;
• ацидоз и коматозные состояния;
• физические высокие нагрузки.
142. ЛЕЙКОЦИТАРНАЯ ФОРМУЛА
Сдвиг лейкоцитарной формулы влево с омоложением(в крови присутствуют метамиелоциты, миелоциты,
промиелоциты, миелобласты, эритробласты):
• хронические лейкозы;
• эритролейкоз;
• миелофиброз;
• онкологические метастазы;
• острые лейкозы;
• коматозные состояния.
143. ЛЕЙКОЦИТАРНАЯ ФОРМУЛА
Сдвиг лейкоцитарной формулы вправо (сниженоколичество палочкоядерных нейтрофилов в сочетании с
гиперсегментированными ядрами нейтрофилов):
• мегалобластная анемия;
• болезни почек и печени;
• состояния после гемотрансфузии.
144. ЛЕЙКЕМОИДНАЯ РЕАКЦИЯ
Характеризуется временным значительным увеличением числалейкоцитов, их незрелых форм и как правило, но не всегда,
повышением общего числа лейкоцитов в периферической крови
на какой-либо раздражитель.
• Причины:
• внедрение вирусов, м/о, паразитов,
• БАВ, при распаде тканей, опухолей,
• при гемолизе эритроцитов,
• инфекционно-аллергические реакции.
145. ЛЕЙКЕМОИДНАЯ РЕАКЦИЯ
Частолейкемоидные
реакции
сопровождаются
увеличением числа зрелых форм лейкоцитов и их
функциональной
активности,
это
обуславливает
повышение
специфической
и
неспецифической
резистентности организма, но в случае преобладания в
крови незрелых форм, функциональная активность
которых низка, резистентность организма снижается.
Лейкемоидная реакция не трансформируется в лейкоз.

medicine
medicine








